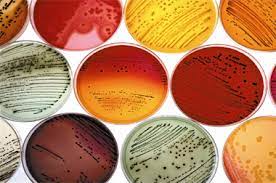
آئوزین متیلن بلو آگار

آئوزین متیلن بلو آگار(EMB)
آئوزین متیلن بلو آگار| Eosin Methylene Blue Agar
آئوزین متیلن بلو آگار به انگلیسی Eosin Methylene Blue Agar به اختصار EMB یک نوع آگار و محیط سلکتیو و افتراقی می باشد که در آزمایشگاه های تشخیص طبی نیز مورد استفاده قرار می گیرد.
تاریخچه آئوزین متیلن بلو آگار
این ترکیب برای اولین بار در سال 1916 توسط Halt-Hariss و Teague برای ایجاد تمایز میان باکتری های گرم منفی موجود در مواد غذایی، مواد لبنی، و همچنین نمونه های بالینی فرموله گردید که در فرمول آن محتوی ساکارز و لاکتوز بعنوان مواد مغذی این باکتری وجود داشت سپس در سال 1918 شخصی به نام لوین (Levine) با حذف کردن محتوای ساکارز از محتوی فرمول و افزایش میزان لاکتوز این فرمول را اصلاح نمود که به نام این شخص نیز شناخته می شود و بیشتر برای جداسازی و شناسایی باسیل های روده ای طراحی گردید.
EMB از پپتون، لاکتوز، دی پتاسیم فسفات، آئوزین، متیلن بلو و آگار ساخته می شود. همچنین EMB نیز وجود دارند که فاقد لاکتوز می باشند. وجود نمک فسفات باعث بافری شدن pH محیط می شود.
EMB متشکل از یک واحد ائوزین و 6 واحد متیلن بلو است. این ماده یک عامل متمایز کننده میان کلیفرم های مدفوعی با سایر کلیفرم ها مطابق شماره استاندارد ISO 20115 می باشد.
انجمن بهداشت عمومی آمریکا برای آزمایش های لبنی و غذایی و صنایع تصویه آب، استفاده از این آگار را توصیه نموده است.
اساس عملکرد آئوزین متیلن بلو آگار
اساس عملکرد آن بر پایه تخمیر لاکتوز توسط باکتری های گرم منفی می باشد. با تخمیر لاکتوز، مقداری اسید به عنوان محصول جانبی تخمیر در محیط آزاد می شود که باعث اسیدی شدن و پایین آمدن pH محیط می شود که این امر سبب می شود باکتری های گرم مثبت امکان رشد نداشته باشند و تا حدی از رشد آن ها جلوگیری می شود.
در شرایط اسیدی رنگ سبز متالیک درخشنده به خود می گیرد این محیط کشت یک بستر مناسب جهت افتراق میان محصولات تخمیری می باشد. باکتری های تخمیر کننده لاکتوز که از نوع گرم منفی هستند با تخمیر لاکتوز و تولید اسید ایجاد یک کمپلکس بنفش تیره می کنند، که با درخشش فلزی سبز روشن همراه است. که این رنگ سبز نشان دهنده تخمیر خوب لاکتوز یا ساکارز می باشد که بیانگر وجود کلیفرم مدفوعی می باشد. دلیل ایجاد این رنگ ایجاد پیوند آمیدی بین آئوزین و متیلن بلو در اثر تولید اسید با فعالیت بالای این کلیفرم می باشد. سایر کلیفرم های با فعالیت پایین تر به دلیل توانایی تولید اسید کمتر فاقد این رنگ می باشند.
وجود آئوزین به همراه متیلن بلو از رشد باکتری های گرم مثبت جلوگیری می کند. زمانی که محیط اسیدی می شود متیلن بلو از رشد باکتری های گرم مثبت جلوگیری می کند و آئوزین تغییر رنگ می دهد. اگر تخمیر آهسته تر و ملایمتر صورت پذیرد رنگ قهوه ای مایل به صورتی ایجاد می شود. که نشان دهنده کلبسیلا است .
باکتری هایی چون شیگلا و سالمونلا و سودوموناس توانایی تخمیر لاکتوز را ندارند لاکتوز غیر تخمیری pH را با آمین زدایی پروتئین ها افزایش می دهد تدر نتیجه تولید کلنی های شفاف، بی رنگ، و یا کهربایی می کنند که به راحتی از کلیفرم ها متمایز می شود.
باکتری انتروباکتر آئروژن نسبت به کلبسیلا تخمیر بیشتری روی لاکتوز انجام می دهند بنابر این تولید رنگ صورتی پر رنگ کدر می نماید.
افزودن ساکارز به محیط آگار برای تمایز با وضوح بالاتر میان کلیفرم ها گنجانده شد. زیرا کلیفرم ها قادر به تخمیر لاکتوز نبوده ولی ساکارز را می توانند تخمیر کنند.
همچنین باکتری های گرم منفی سخت رشد و باکتری های گرم مثبت با اسیدی شدن محیط ایجاد رسوب می کنند بنابرای میزان رسوب تولید شده نمایانگر فعالیت باکتری ها و تخمیر لاکتوز هستند.
درباره ما
شركت مينا تجهيز آريا با سالها تجربه و با استفاده از تخصص،تعهد، تجربه و دانش هاي نوين اقدام به تهيه، توزيع مواد شیمیایی ( آزمایشگاهی ، صنعتی ) و تجهيز لوازم آزمايشگاهي، شيشه آلات و كليه ملزومات آزمايشگاهي از شركت هاي داخل و خارج كشور نموده است.
برای پرسش و پاسخ و دریافت قیمت و موجودی با کلیک روی لینک زیر به تلگرام شرکت پیام دهید
آدرس : تهران - میدان توحید- خیابان امیر لو(نبش کوچه خودرو) - پلاک 42- طبقه دوم - واحد5
ایمیل : minatajhiz_aria@yahoo.com
شماره ها تماس : 02166901187 - 02166900058
شماره ه همراه :09362048289 - 09927282910
شماره های واتس آپ ، ایتا ، تلگرام و روبیکا :09362048289 - 09927282910


